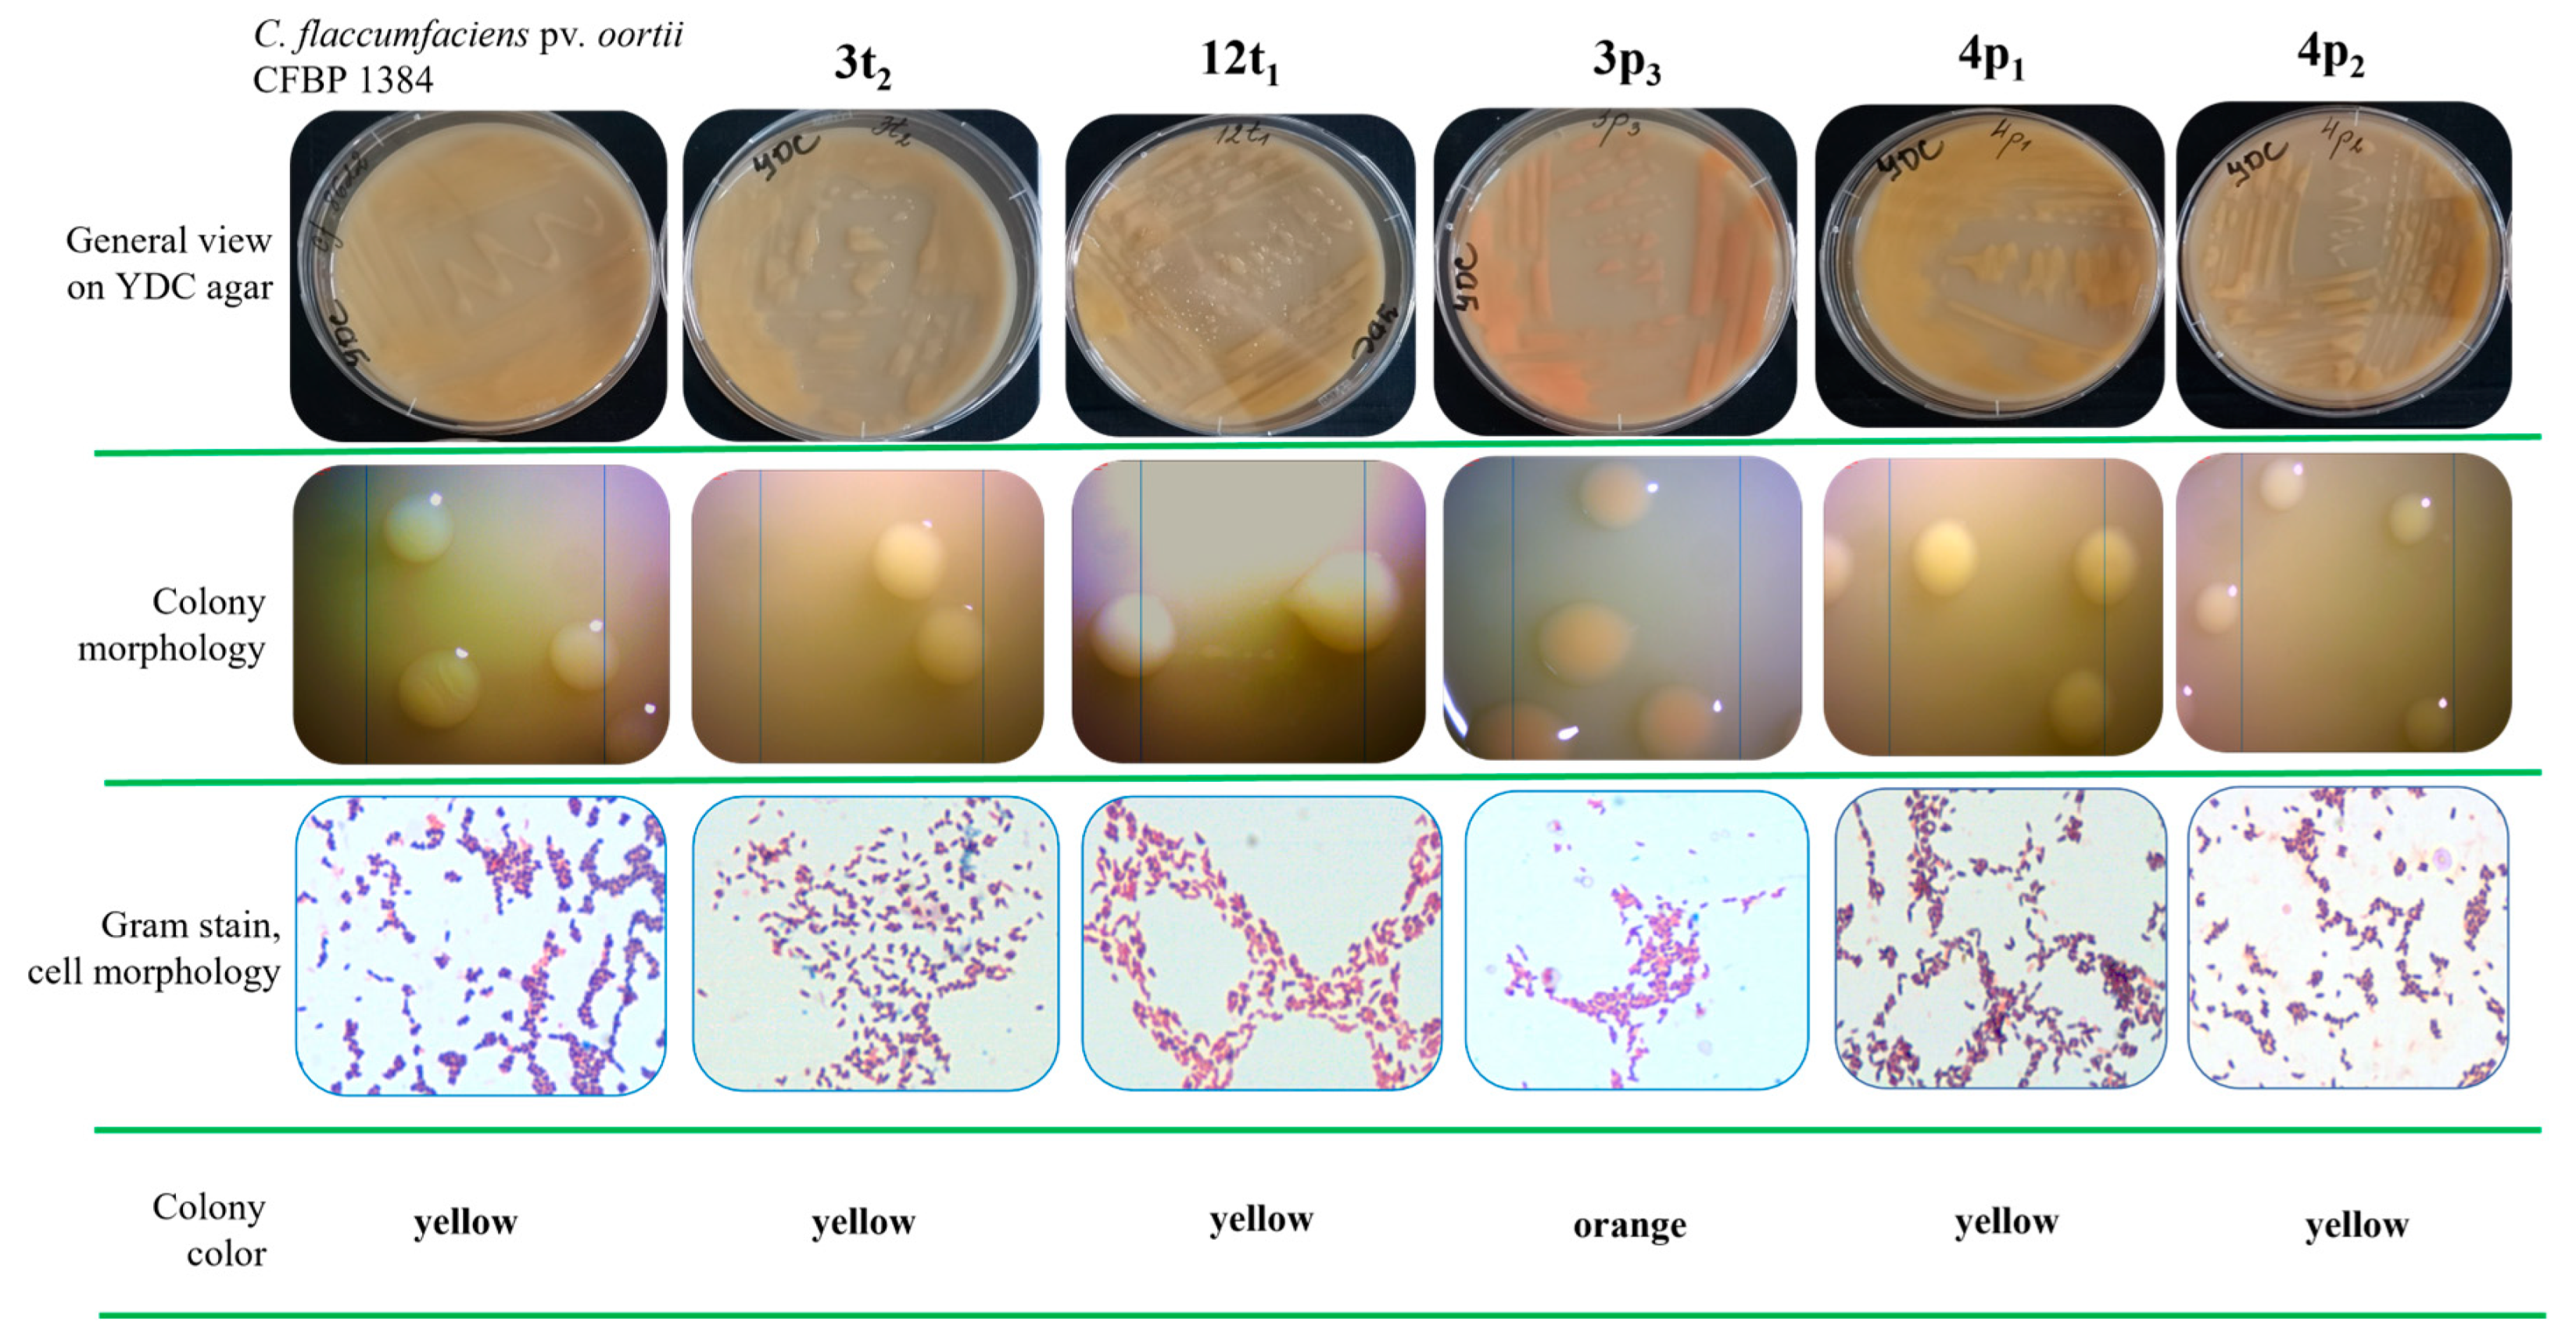
Pathogens 13 00483 g002 Pathogens 13 00483 g002
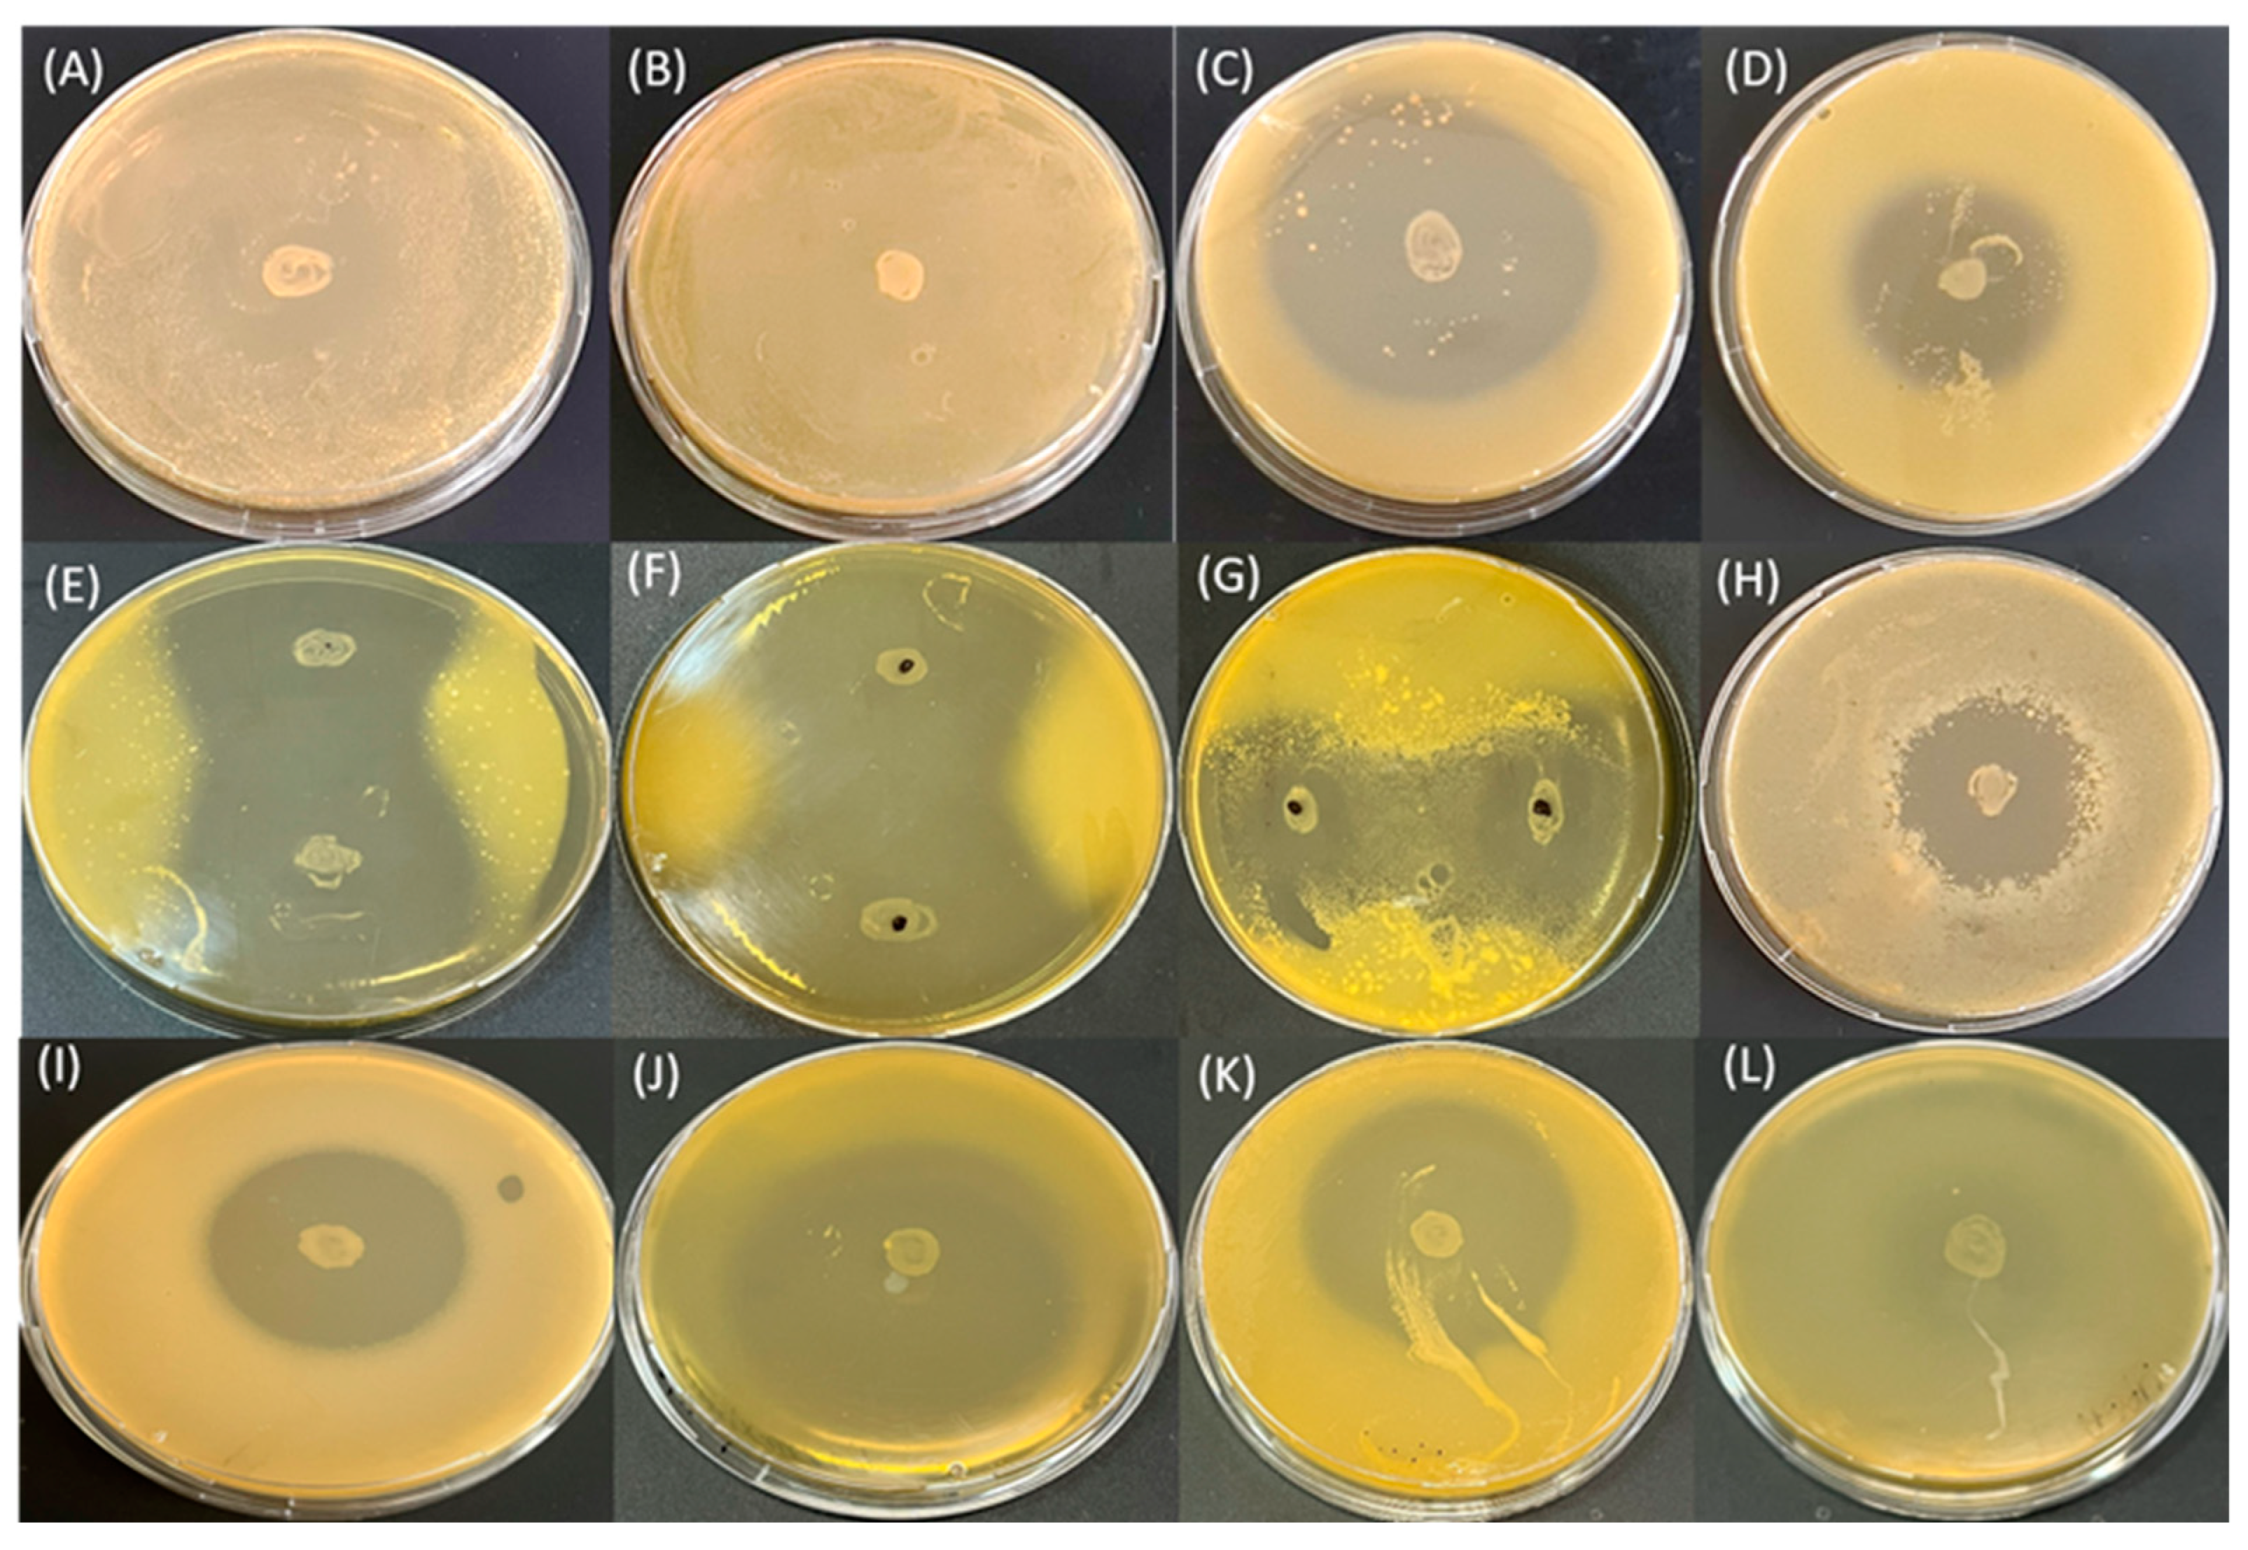
Pathogens 13 00483 g004 Pathogens 13 00483 g004

Abstract
This study aims at the identification and characterization of five actinobacterial strains with presumed belonging to the species Curtobacterium flaccumfaciens isolated from tomato and pepper plants, and establishing the potential role of both plants as natural reservoirs of this phytopathogen. Species identification was performed via MALDI-ToF MS, 16S rDNA sequencing and PCR. The strains were Gram-positive with a coryneform cell shape having yellow/orange-pigmented colonies; positive for catalase and esculin, and starch and casein hydrolysis; oxidase-, urease-, indole- and nitrate-reduction-negative and were strictly aerobic. All isolates produced antimicrobial substances against various phytopathogenic bacteria. Tomato and pepper plants were artificially infected with newly isolated strains in order to establish their role as natural reservoirs of the bacteria. Morphological alterations were observed only in the tomato plants, with defoliation of the first two to four leaves at the 28th day. Then, viable coryneform bacterial isolates (n = 73) were successfully re-isolated only from the stems of the infected plants. The similarity between the re-isolates and the respective initial isolates was confirmed phenotypically and genotypically by RAPD-PCR, confirming that solanaceous vegetables can act as reservoirs of C. flaccumfaciens. This is the first report of C. flaccumfaciens in Bulgaria.
1. Introduction
Members of the family Microbacteriaceae (order Actinomycetales, class Actinobacteria) are known to inhabit diverse ecological niches (aqueous and terrestrial), having an epiphytic, endophytic or pathogenic lifecycle [1]. They are aerobes with a Gram-positive pleomorphic cell shape (coryneform) and a high G+C content. The species comprise characteristics, like a specific B-type cell wall structure and unsaturated respiratory menaquinones, which separates them from the other actinobacteria [2]. According to the List of Prokaryotic names with Standing in Nomenclature (LPSN), the family consists of more than 60 genera [3] (accessed in May 2024).
The genus Curtobacterium is a member of the family Microbacteriaceae and was first described by Yamada and Komagata in 1972. It includes pathogenic and non-pathogenic species [4]. According to International Committee on Systematics of Prokaryotes (ICSP) and the International Code of Nomenclature of Prokaryotes (ICNP), the current composition of the genus comprises of 18 species with validly and not validly published names [3,4,5,6,7,8,9,10,11,12,13].
Among these species, two are known as plant pathogens, Curtobacterium flaccumfaciens (Cf) and the recently described Curtobacterium allii, causing onion bulb rot [13,14]. The latter species has been recently proposed for reclassification as a pathovar of C. flaccumfaciens [14]. The species C. flaccumfaciens includes pathogenic and non-pathogenic strains [15] as well as strains associated with human diseases [16,17]. On the other hand, data regarding the role of C. flaccumfaciens as a plant-beneficial endophyte, reducing disease symptoms, has also been reported [18,19]. Several pathovars of the species are known to be pathogenic and to cause bacterioses on various plants, including C. flaccumfaciens pv. ilicis (bacterial blight of American holly), C. flaccumfaciens pv. betae (silvering disease of red beet), C. flaccumfaciens pv. oortii (bacterial wilt and spot of tulip), C. flaccumfaciens pv. poinsettiae (bacterial canker of poinsettia) and C. flaccumfaciens pv. flaccumfaciens (Cff) (bacterial wilt on dry bean) [15]. Due to its seed-borne nature, the latter pathovar of the species is considered a pathogen of high risk and is included in the A2 list of quarantine pests by the EPPO [20]. Additionally, the pest is under strict control as a dangerous microorganism and is prohibited from entering and spreading throughout the protected zones of Greece, Portugal and Spain if it is found on Phaseolus vulgaris (common bean) and Dolichos seeds [21].
Apart from its common habitats, representatives of the species C. flaccumfaciens have been isolated from diverse plant species that are not among its known susceptible hosts. The role of such alternative and alternate host plants as natural reservoirs of this coryneform bacterium is considered of great importance and has recently been the subject of serious investigation. Among them, tomato, bell pepper, eggplant, sunflower, wheat, etc., could be mentioned [22,23,24]. In this regard, clarifying the ability of the pathogenic bacteria to persist and survive in various uncommon habitats sheds light on the probability that they will exert their pathogenic potential and expand their host range. Supporting this hypothesis is a study reporting that two strains of C. flaccumfaciens have caused chlorosis and leaf death on maize under greenhouse experiments [22]. Since maize is not one of C. flaccumfaciens’ known susceptible hosts, this shift in the bacterial pathogenicity is quite concerning and has prompted the need for additional research in this area.
Over the past few decades, knowledge about the composition of C. flaccumfaciens has accumulated, demonstrating that it is a complex species. In most of the cases, the identification at the species level has been conducted via polyphase approaches based on the comparison of the sequences of 16S rDNA [25,26,27,28,29,30], MALDI-ToF MS [17,28,29] and PCR methods [22,23,30]. The most applied PCR protocols are usually based on amplification with pathovar-specific primers specifically targeting C. flaccumfaciens pv. flaccumfaciens [31,32]. Various molecular techniques have been conducted over the years aimed at establishing the genetic structure inside the species. As a result, great genetic diversity has been established based on DNA fingerprint methods, such as AFLP, rep-PCR and PFGE, and multilocus sequence analyses (MLSAs) [15,22,33,34,35]. Recently, a significant reclassification within the species C. flaccumfaciens has been proposed based on the comparison of the whole-genome sequences of numerous Curtobacterium strains and the evaluation of the average nucleotide identity (ANI) and digital DNA–DNA hybridization [14]. The orange-pigmented strains of C. flaccumfaciens pv. flaccumfaciens have been reclassified as Curtobacterium aurantiacum sp. nov., the orange- and pink-pigmented strains of C. flaccumfaciens pv. poinsettiae were reclassified as C. poinsettiae sp. nov., C. allii [13] was reclassified as C. flaccumfaciens pv. allii pv. nov. and Curtobacterium flaccumfaciens pv. basellae [36] was reclassified as Curtobacterium citreum pv. basellae. C. citreum and Curtobacterium albidum were considered the same species [14].
Currently, C. flaccumfaciens and Cff in particular are considered absent in Bulgaria according to The Bulgarian National Plant Protection Organization (Service) (NPPO), although a few records concerning the pathogen have been published almost 40–50 years ago by Radkov and Nedelchev in 1975 and Boyadzhiev and Kakumkova in 1985, according to the EPPO Global Database [37]. Since then, the species has not been reported in Bulgaria, and this study is the first report for the last almost five decades. Thus, the main aim of this study is to announce, for the first time in Bulgaria, the isolation and species identification and characterization of newly isolated bacterial strains with presumed belonging to the species C. flaccumfaciens. The species was found accidentally on tomato and pepper plants with symptoms of bacterioses, and our purpose was to establish the potential role of Solanum lycopersicum (cv. Ideal) and Capsicum annuum (cv. Zlaten medal) as natural reservoirs of this bacterium.
2. Materials and Methods
2.1. Bacterial Strains Used in This Study
For the aims of this study, several species of bacteria were used as test microorganisms in the experiment for the production of antimicrobial substances (AMSs): phytopathogenic bacteria Xanthomonas euvesicatoria strains 40f (tomato flower isolate), 269p (pepper isolate) and 105t (tomato isolate); Xanthomonas vesicatoria strain 124t (tomato isolate) and Xanthomonas gardneri strain 62t (tomato isolate), which have been previously characterized and their pathogenicity to sensitive plants (tomato and pepper) has been evaluated [38,39,40]; Clavibacter michiganensis subsp. michiganensis CFBP 2492; and plant-associated bacterium Pseudomonas putida ATCC 12633. The type strain C. flaccumfaciens pv. oortii (Cfo) CFBP 1384 was also included in the analyses as the control bacterial strain.
2.2. Plant Material and Isolation of Coryneform Bacterial Strains
Plant samples (S. lycopersicum L, C. annuum L and Capsicum frutescens) with symptoms of diseases were randomly collected from a crop field and used for phytopathogenic bacteria isolation [41]. The different parts of the diseased plants (Figure 1) were separated, rinsed with sterile dH2O and processed with iodine alcoholic solution to remove the epiphytic microflora.
Figure 1.
Plant samples used for the isolation of the bacteria.
The zones with disease symptoms but surrounded by healthy tissue were cut off with sterile scissors, homogenized in sterile saline (NaCl, 0.9%), incubated for 30 min at room temperature and periodically vortexed every 5 min. The resulting suspensions were 10-fold diluted in sterile saline and 100 µL of each dilution was surface plated on yeast dextrose calcium (YDC) agar (HiMedia, Mumbai, India). The Petri dishes were cultivated aerobically at 28 °C for 48–72 h. The initial selection was performed based on the colony morphology formed on the YDC agar after cultivation—yellow or orange pigmentation, shiny and smooth. Pure bacterial cultures were obtained after the double re-cultivation of selected single colonies on potato sucrose agar (PSA) (potato extract, 200 g/L; sucrose, 20 g/L; agar, 15 g/L; dH2O, 1 L; pH = 7.0). The obtained bacterial strains were stored at 4 °C for further analyses.
2.3. Phenotypic Characterization of the Bacterial Isolates
Several key biochemical characteristics, recommended by the EPPO, were studied for all newly isolated strains [20]: aerobic/anaerobic growth, hydrolysis of esculin, starch and casein, production of urease, catalase and cytochrome c oxidase, production of indole from tryptophan and nitrate reduction as well as Gram staining. Log-phase cultures (obtained after overnight cultivation at 28 °C on PSA) were used for the determination of phenotypic characteristics. Bacterial suspensions, 108 CFU/mL (MacFarland units, 1.3), were prepared in normal saline and used for the analyses. The ability for esculin hydrolysis was determined on bile esculin agar (Bioprepare Microbiology, Markopoulo, Greece). The ability for starch hydrolysis was evaluated on starch agar (beef extract, 3 g/L; peptone, 5 g/L; soluble starch, 10 g/L; agar, 15 g/L, dH2O, 1 L; pH of 7.5) and casein hydrolysis was evaluated on skim milk agar (beef extract, 3 g/L; peptone, 5 g/L; skim milk, 15 g/L; agar, 15 g/L, dH2O, 1 L; pH of 7.5). The motility, indole and urease medium (MIU medium) (LQ092, HiMedia, Mumbai, India) was used for the determination of urease and indole production. The catalase production was established by the addition of 3% H2O2 to the culture. For the determination of the production of cytochrome c oxidase, Bactident Oxidase test strips (Merck KGaA, Darmstadt, Germany) were used. The ability of the tested strains to reduce nitrates were evaluated on semi-solid nitrate media (peptone, 5 g/L; yeast extract, 4 g/L; agar 3 g/L; KNO3, 1 g/L; pH = 7.0). The inoculated media were cultivated at 28 °C for 48–72 h. The presence of either nitrates or nitrites after the cultivation period was tested colorimetrically using nitrate test strips (10–500 mg/L (NO3−) (Merck KGaA, Darmstadt, Germany).
2.4. Isolation of Chromosomal and Plasmid DNA from the Strains
All strains were aerobically cultivated overnight in 50 mL of Luria Bertani (LB) broth at 28 °C in a rotary shaker (RSLAB-7PRO, Auxilab, Polígono Morea Norte, Beriáin (Navarra), ESPAÑA) to obtain the log-phase cultures. For the isolation of chromosomal DNA (cDNA) from the strains, aliquots of one milliliter of the resulted bacterial cultures were centrifuged at 8000 × g for 10 min to collect the bacterial pellet. The cDNAs were extracted using commercial DNA isolation kits, the GenEluteTM Bacterial Genomic DNA Kits (Merck KGaA, Darmstadt, Germany). For the isolation of the plasmid DNAs from the strains, 5 mL of the resulted bacterial cultures were used and the bacterial pellets were collected as described above. The plasmids were extracted with the EZNA Plasmid DNA Mini Kit I (Omega Bio-Tek, Inc., Norcross, GA, USA) according to the recommendations of the manufacturer. The quality and quantity of the obtained DNAs were checked electrophoretically on 1% agarose gel and on the spectrophotometer/fluorometer DeNovix DS-11 FX+ (DeNovix Inc., Wilmington, DE, USA), respectively. For the complete lysis of the cells, 2 μL of 1000 units/mg mutanolysin (Merck KGaA, Darmstadt, Germany) was added at the enzyme lysis step. The isolated DNAs were stored at −20 °C and used in the further analyses.
2.5. Identification of the Isolated Bacteria
A polyphase approach was used for the identification of the newly isolated strains, with MALDI-ToF (Matrix-Assisted Laser Desorption/Ionization Time-of-Flight) mass spectrometry (MS) [41], 16S rDNA sequencing and PCR with primers CffFor2/CffRev4, specific for the detection of Cff [31]. The 16S rDNA genes of all isolates were amplified using the primer pair 27F/1492R [42]. PCR reactions were carried out in a total volume of 50 µL, containing 22 µL of ultra-pure H2O, 25 µL of PCR mixture 2 × iProof HF MasterMix (BioRad, Laboratories Inc., Sofia, Bulgaria), 1 µL of each primer (10 pmol/µL) and 1 µL of cDNA. The reaction conditions were as follows: initial denaturation at 94 °C for 7 min, followed by 30 cycles of 94 °C for 45 s, 57 °C for 1 min, 72 °C for 1 min and final elongation steps at 72 °C for 10 min. The PCR products were visualized by 1.5% agarose gel electrophoresis. Purified PCR products were sequenced in Macrogen Europe, Meibergdreef 57 1105 BA, Amsterdam, The Netherlands. The obtained sequences were subjected to comparative analyses using BLASTN on NCBI (accessed in April 2024) and 16S-based ID on EzBioCloud databases [43] (accessed in April 2024). The genome assemblies of a set of type and non-type strain members of the family Microbacteriaceae were downloaded from NCBI and their 16S rDNA genes were extracted. They were aligned together with the 16S rDNA sequences obtained from our strains using a Clustal Omega 1.2.2 using the mBed fast algorithm. A phylogenetic tree was built with FastTree v 2.1.11 using the Generalized Time-reversible genetic distance model. The resulting tree was annotated with iToL v 6.9 [44].
The pathovar-specific PCR (primers CffFor2/CffRev4) was performed according to Tegli et al. [31], and chromosomal and plasmid samples were used as DNA templates in separate reactions.
All PCR reactions were carried out in MJ Research PTC-200, Peltier Thermal Cycler (Hampton, NH, USA).
2.6. Evaluation of the Antimicrobial Activity of the Isolates
The ability of our C. flaccumfaciens isolates to produce AMSs was carried out according to procedure described by Osdaghi et al. [22] with slight modifications. All strains isolated in this study along with the type strain C. flaccumfaciens pv. oortii CFBP 1384 were tested for extracellular production of AMSs against various phytopathogenic and plant-associated test bacteria (see Section 2.1). The potential producers were spot-inoculated on the surface of 20 mL of yeast peptone glucose agar (YPGA) medium (yeast extract, 7 g/L; peptone, 7 g/L; glucose, 7 g/L; agar 18 g/L; dH2O, 1 L) and incubated at 28 °C for 48 h. The test bacteria were cultivated on PSA until the obtainment of the log-phase culture, after which fresh bacterial suspensions with a concentration of 108 CFU/mL (MacFarland units, 1.3) were prepared in normal saline. An amount of 200 µL of each suspension, separately, were mixed with 3 mL of soft YPGA (agar content, 4.5 g/L) medium and poured onto the surface of the Petri dishes with the previously cultivated AMS producers (our strains). The Petri dishes were cultivated for 48 h at 28 °C and the appearance of clear zones around the spots were considered as a positive result for AMS production from the respective strain. For the purposes of this study, the sensitivity of the test bacteria to the produced AMSs, determined on the basis of the diameter of the inhibitory zones, was described with the following 4 groups: ≥41 mm, strong sensitivity (SS); 21–40 mm, intermediate sensitivity (IS); 7–20 mm, weak sensitivity (WS); 0–6 mm, resistance (R). The experiments were performed in triplicate.
2.7. Artificial Infection of Tomato and Pepper Plants
Seeds of S. lycopersicum L. cv. Ideal and C. annuum L. cv. Zlaten medal were surface-disinfected with a 0,03% solution of KMnO4 and sown in a sterilized (130 °C for 30 min) commercial soil mixture (Agricult, St. Ioannou Theologou 115, Acharnai, Greece). The seedlings were grown in climatic chamber under controlled conditions (a 26 ± 2 °C temperature, a 16/8 h day/night photoperiod, a light intensity of 70–90 µmol/m2/s and 60–70% relative air humidity) until reaching the 3–4th leaf stage. The newly isolated bacterial isolates (3t2, 12t1, 3p3, 4p1 and 4p2) were grown in PSA at 28 °C overnight to obtain the log-phase cultures. The bacterial suspensions were prepared in sterile dH2O and adjusted to 108 CFU/mL (MacFarland units, 1.3). The artificial infections of the plants were performed according to the procedure described by Osdaghi et al. [22]. Each plant was individually infected: tomato plants with strains 3t2 and 12t1 and the pepper plants with strains 3p3, 4p1 and 4p2. Sterile dissecting needles were dipped into the bacterial suspensions and, after that, the plants were pierced through the first internode. The control plants were treated the same way but, instead of bacterial suspensions, sterile dH2O water was used. The infected test plants were cultivated for a period of 28 days under the controlled climatic chamber conditions described above and observed for the appearance of any morphological changes every 7 days. The experiments were conducted in triplicate with three plants per each individual infection.
2.8. Re-Isolation of C. flaccumfaciens Strains from the Artificially Infected Plants
After the examined period (28 days), the plants were analyzed for the presence of inoculated C. flaccumfaciens strains in the aboveground plants’ parts (leaves, stems and petioles). Each part of the particular plant was finely chopped with a scalpel and homogenized in sterile saline. The resulting homogenates were incubated at room temperature for 30 min with strong vortexing at every 5 min. After that, the suspensions were 10-fold diluted in normal saline and aliquots of 100 µL of each dilution were surface-inoculated on YDC agar. The Petri dishes were incubated at 28 °C for 24–72 h until visible bacterial growth was observed. All samples were carefully checked and only single colonies, corresponding to the initial bacterial isolates, were isolated on PSA. Pure cultures were obtained after two consecutive re-cultivations on PSA. The isolates were stored at 4 °C and used for further analyses.
2.9. Determination of the Similarity between the Initial Isolates and the Re-Isolates
Micromorphological, biochemical and molecular characterization was performed to determine the similarity between the initial bacterial isolates used for the artificial infection of the plants and the respective re-isolates. All re-isolated bacteria were Gram-stained and microscopically observed. Aerobic/anaerobic growth as well as catalase and oxidase activity were also determined. The RAPD-PCR approach was optimized for the purposes of this study in order to determine the unique molecular pattern of each initial strain. The similarity between the initial strains and the respective re-isolates was performed on the bases of comparisons of the obtained RAPD-PCR patterns for each individual strain and its respective re-isolates before and after the artificial infection of the plants. The type strain C. flaccumfaciens pv. oortii CFBP 1384 was included as the control. The extracted cDNA from all initial isolates and re-isolates were amplified with primer CUGEA 6 (5′–GGA AGC TTC G–3′) [45]. The reactions were conducted in a total final volume of 25 µL, containing 16.5 µL of sterile ultra-pure water, 6.5 µL of VWR Red Taq polymerase master Mix (VWR International bvba/sprl, Haasrode Researchpark Zone 3, Geldenaaksebaan 464 B-3001, Haasrode Belgium), 1 µL of primer CUGEA 6 and 1 µL of the DNA sample. The PCR reactions were performed in the MJ Research PTC-200, Peltier Thermal Cycler, under the following conditions: initial denaturation at 95 °C for 10 min, followed by 30 cycles of denaturation at 94 °C for 1 min, 42 °C for 1 min and 72 °C for 1.3 min. The final elongation was at 72 °C for 10 min. The resulting amplicons were separated and visualized by 2% agarose gel electrophoresis for 50 min at 100 V.
3. Results
3.1. Plant Samples and Isolation of the Bacteria
Recently, during a routine study aimed at the isolation, characterization and identification of phytopathogenic bacteria associated with bacterial spot and canker on solanaceous vegetables (C. michiganensis subsp. michiganensis, X. euvesicatoria pv. euvesicatoria, X. euvesicatoria pv. perforans, X. vesicatoria and X. gardneri) in Bulgaria, five other isolates (designated as 3t2, 12t1, 3p3, 4p1 and 4p2) with a similar macromorphology to the species mentioned above were also isolated. The isolates were obtained from different parts of tomato and pepper plants showing symptoms of bacterioses (Figure 1). Strain 3t2 was isolated from sample T3 (tomato stem), strain 12t1 was isolated from sample T12 (tomato seeds originating from sample T8, representing ripe mature tomato fruit collected from the same vegetable field), strain 3p3 was isolated from sample P3 (sweet pepper leaf) and strains 4p1 and 4p2 were isolated from sample P4 (chili pepper leaf) (Figure 1). Our preliminary analyses showed that these isolates did not belong to any of the common pathogens mentioned above. The morphology of the colonies on the YDC agar of all isolates were very close to those of type strain C. flaccumfaciens pv. oortii CFBP 1384. Four of the isolates (3t2, 12t1, 4p1 and 4p2) formed yellow-pigmented and one (3p3) formed orange-pigmented smooth and shiny colonies (Figure 2).
Figure 2.
Morphological characterization of the isolates.
3.2. Phenotypic Characterization of the Isolates
All strains were Gram-positive (Figure 2), with a coryneform cell morphology (short rods), and were catalase-positive and oxidase-negative. The strains were strictly aerobic, capable of hydrolyzing esculin, starch and casein, and negative for urease and indole production. None of the tested strains had the ability to reduce nitrates and nitrites. The obtained results showed that the isolates can be attributed to the group of phytopathogenic coryneform bacteria [20,22].
3.3. Identification of the Isolates
All five isolates were identified as C. flaccumfaciens by MALDI-ToF MS. The 16S rDNAs obtained from our strains were sequenced and processed to clear the low-quality regions, and after that were deposited at the GenBank with approved accession numbers (AN) (Table 1). The bioinformatic analyses of our 16S rDNA sequences showed that the five strains shared very high similarity (>99%) with the species C. flaccumfaciens pv. flaccumfaciens strain 1037, GenBank accession number CP041259.1 [46] (according to the NCBI), and with C. flaccumfaciens type strain LMG 3645, GenBank accession number AJ312209 (according to EzBioCloud) [7]. The score values (SVs) from the MALDI-ToF and the similarity percentages obtained after nucleotide blast analyses are shown in Table 1.
Table 1.
Species identification of the isolated strains.
Additionally, a phylogenetic analysis based on 16S rDNA gene alignment, comparing our C. flaccumfaciens strains reported in this study to other members the genus Curtobacterium and family Microbacteriaceae, was made. The results showed that our strains clustered together with C. flaccumfaciens and had less distance to the C. flaccumfaciens species compared to other Curtobacterium species. This corresponded with the morphological examinations and MALDI-ToF (Figure 3).
Figure 3.
Phylogenetic tree constructed based on 16S rDNA gene alignment, comparing C. flaccumfaciens strains isolated by us and reported in this study to other species within the genus Curtobacterium and family Microbacteriaceae.
Plasmid DNAs were successfully isolated from all of our isolates as well as from the type culture Cfo. For the PCR amplification with primers CffFor2/CffRev4, chromosomal and plasmid DNAs were used as templates separately. The obtained results showed that positive amplifications (approximately 306 bp of amplified product) were observed in the plasmid DNAs of all tested strains except for strain 12t1. No amplification products were observed in the agarose gel electrophoresis when cDNA was used as template in the PCR reactions.
3.4. Evaluation of the Ability of Newly Isolated C. flaccumfaciens Strains to Produce AMSs
The newly isolated C. flaccumfaciens strains and the type strain C. flaccumfaciens pv. oortii CFBP 1384 were tested for the ability to produce AMSs against Gram-negative and Gram-positive bacteria. The obtained results showed that all isolates inhibited the growth of all tested phytopathogenic and plant-associated bacteria to varying degrees (Figure 4). The susceptibility of Gram-negative bacteria to the AMSs produced by the investigated C. flaccumfaciens strains was greater than that observed for the Gram-positive test bacteria.
Figure 4.
Production of antimicrobial substances (AMSs) from C. flaccumfaciens isolates against various test bacteria. Spot cultures in the center of the Petri dishes are AMS producers. (A) Cf 3p3 (AMS producer), Cmm CFBP 2492 (test microorganism); (B) Cf 4p1 (AMS producer), Cmm CFBP 2492 (test microorganisms); (C) Cf 3p3 (AMS producer), X. gardneri 62t (test microorganism); (D) Cf 12t1 (AMS producer), X. euvesicatoria 105t (test microorganism); (E) Cf 4p1 (AMS producer), X. vesicatoria 124t (test microorganism); (F) Cf 4p2 (AMS producer), X. euvesicatoria 105t (test microorganism); (G) Cf 3t2 (AMS producer), X. vesicatoria 124t (test microorganism); (H) Cf 3p3 (AMS producer), P. putida ATCC 12633 (test microorganism); (I) Cfo CFBP 1384 (AMS producer), P. putida ATCC 12633 (test microorganism); (J) Cfo CFBP 1384 (AMS producer), X. euvesicatoria 269p (test microorganism); (K) Cfo CFBP 1384 (AMS producer), X. vesicatoria 124t (test microorganism); (L) Cfo CFBP 1384 (AMS producer), Cf 12t1 (test microorganism).
All tested Gram-negative bacteria showed SS or IS to the AMSs produced by our Cf strains and by Cfo CFBP 1384. The largest inhibition zones (70 mm) were formed by Cf strains 3t2 and 12t1 (isolated from tomato), and by Cfo CFBP 1384 against the phytopathogenic bacteria X. gardneri strain 62t and X. euveicatoria strain 269p (Table 2). These two species of Gram-negative phytopathogenic bacteria were found to be the most sensitive to AMSs produced by the producer strains. The ability of Cf strains isolated from pepper (3p3, 4p1 and 4p2) to inhibit the growth of the tested the phytopathogenic and plant-associated bacteria was also very strong, although the inhibition zones were smaller than those formed by Cf strains isolated from tomato (3t2 and 12t1). The plant-associated species P. putida ATCC 12633 showed IS to AMSs produced by all Cf strains (Figure 4). The species C. michiganensis subsp. michiganensis CFBP 2492 (Cmm) showed resistance to almost all AMSs produced by the Cf isolates, as only one isolate (3p3) and Cfo CFBP 1384 inhibited its growth (inhibition zones of 20 and 35 mm, respectively).
Table 2.
Action of antimicrobial substances (AMSs) produced by C. flaccumfaciens isolates, reported in this study, against Gram-negative and Gram-positive bacteria.
The evaluation of the antibacterial activity of the Cf isolates against each other showed that the strain 4p2 had the most pronounced effect against four of the isolates—12t1, 3p3, 4p1 and 3t2. The first three of them had intermediate sensitivity and the fourth (3t2) had weak sensitivity to the AMSs produced by strain 4p2 (Table 2). In turn, isolate 4p2 was resistant to the action of the AMSs synthesized by three isolates (3t2, 3p3 and 4p1) and weakly sensitive to the action of strain 12t1. In general, the majority of the Cf strains showed a low sensitivity to each other and to the AMSs synthesized by them. We also found that the isolates 4p1 and 4p2 differed from each other in the antibacterial activity of the AMSs produced by them, as well as in their susceptibility to the AMSs produced by the other producing isolate, despite having a common origin (chili pepper leaf).
3.5. Determination of RAPD-PCR Profiles of the C. flaccumfaciens Isolates
RAPD-PCR analysis was performed in order to establish the specific amplification profiles of our C. flaccumfaciens isolates. This molecular approach was optimized for the purposes of our study for an easy, simple, reliable and fast method for the routine detection of the isolates in artificially infected plants. In the preliminary experiments carried out by us, the RAPD-PCR assays were performed with four CUGEA primers (CUGEA 3, 4, 5 and 6) [45] in order to determine the most suitable primer for strain discrimination. CUGEA 6 was chosen as the most discriminative and was used in the subsequent analyses. The resulting RADP profiles showed high pattern diversity (Figure 5). The amplification profiles of our Cf isolates differed significantly both from each other and from the profile of the type strain Cfo CFBP 1384.
Figure 5.
RAPD–PCR patterns obtained after the amplification of the cDNA of all Cf isolates and C. flaccumfaciens pv. oortii CFBP 1384 (Cfo) with primer CUGEA 6. M—molecular weight marker (SERVA FastLoad 100 bp DNA Ladder, Heidelberg, Germany).
All tested strains formed different RAPD profiles, which means that this approach can be used as a reliable approach in future analyses aimed at the quick recognition of our strains among the surrounding microbiome of the plants after artificial infection and the re-isolation of the strains from the infected plants’ parts. The RAPD profile of the type culture Cfo was described by six fragments (each with an approximate length (bp) of 350, 600, 800, 1000, 1500 and 2800). The profiles of our Cf isolates, expressed in bp, were as follows: Cf 3t2—four fragments (250, 300, 350 and 600), Cf 12t1—three fragments (200, 400 and 800), Cf 3p3—five fragments (500, 1300, 1500, 1600 and about 3000), Cf 4p1—seven fragments (400, 600, 800, 900, 1000, 1500 and 2800) and Cf 4p2—three fragments (1000, 1400 and 2800).
3.6. Artificial Infection of Solanaceous Plants and Re-Isolation of the Inoculated Cf Strains
Tomato and pepper plants were artificially infected with the strains of the putative pathogen Cf we isolated to determine their ability to survive, multiply and persist in the vascular system of these alternate host plants. It was found that, after the 7th day from the beginning of the experiment, the following morphological changes were observed in the tomato plants infected with strains 3t2 and 12t1: yellowing of the first two leaves and the appearance of yellow spots on them, as well as the appearance of wilting. These symptoms increased over the next two weeks. At the 28th day, defoliation of the first four leaves and the first two leaves in the tomato plants infected with the strains 3t2 and 12t1, respectively, was observed (Figure 6). Such symptoms were not observed in the artificially infected pepper plants, and by the end of the examined period, no worrisome morphological changes were observed.
Figure 6.
(A) Artificially infected tomato plants and (B) pepper plants. Red arrows indicate the yellowing of the first two to four leaves on the tomato plants and the defoliation at the 28th day.
After the cultivation period (28 days), all plants were analyzed to detect and confirm the presence of the inoculated Cf strains in them. All aboveground parts of the plants (leaves, stems and petioles) were examined separately. After the incubation of the prepared plant samples on the YDC agar, colonies corresponding to those of the original strains (yellow- or orange-pigmented, smooth and shiny) were observed only in the stem samples obtained from the tomato and pepper plants. Little variation in colony morphology was found on those Petri dishes, most of which were comparable to the colonies of the initial isolates. A total of 73 cultures were re-isolated from single colonies: 16 from stem samples from plants infected with strains 12t1, 3p3, 4p1 and 4p2, separately, and 9 from stem samples of tomato plants infected with strain 3t2. Re-isolates were designated as follows: 3t2/1 to 3t2/9; 12t1/1 to 12t1/16; 3p3/1 to 3p3/16; 4p1/1 to 4p1/16; 4p2/1 to 4p2/16.
3.7. Determination of the Similarity between Re-Isolates and the Initial Cf Strains
The observation under light microscope showed that all re-isolates were Gram-positive. The morphology of the cells was the same as that of the corresponding original Cf strains, which is typical of the coryneform bacteria. The re-isolates were strictly aerobic, catalase-positive and oxidase-negative. The similarity between all 73 re-isolates and the corresponding original strains used for the artificial infection of the test plants was established at the molecular level based on the comparison between the obtained RAPD profiles after the PCR amplification with the primer CUGEA 6. The results showed complete identity between the RAPD profiles of the respective re-isolates and those of the original Cf strains. In Figure 7, the RAPD profiles of the selected re-isolates (3p3/1 to 3p3/9) obtained from the stem samples of pepper plants infected with strain Cf 3p3 and compared to the RAPD profile of the initial Cf 3p3 strain are shown.
Figure 7.
RAPD-PCR patterns of selected re-isolates. 1 to 9—respective re-isolates (3p3/1 to 3p3/9); Cfo—the type strain C. flaccumfaciens pv. oortii CFBP 1384; 3p3—the original Cf strain; M—molecular weight marker (SERVA FastLoad 100 bp DNA Ladder, Heidelberg, Germany).
4. Discussion
The ability of plant pathogenic bacteria to persist, survive and retain pathogenic potential in habitats different from their primary hosts is their important feature enabling them to expand their host range. The role of the alternative and alternate host plants as natural reservoirs of phytopathogenic bacteria has recently been widely discussed. The term “alternative” refers to the hosts that are usually members of the same family as the primary hosts of a particular pathogen, while “alternate” is used when the host is from different family [47]. Many of them reside on various plants without causing disease symptoms. These are the cases with X. perforans and X. gardneri isolated from weeds [48], X. vesicatoria isolated from symptomless weeds associated with tomato production areas [49] and pathogenic Curtobacterium strains isolated from alfalfa, maize, sunflower, tomato, pepper, eggplant and wheat [22,24]. Such residents can rearrange their pathogenicity mechanisms and induce disease symptoms on new susceptible plants, as was the case with two C. flaccumfaciens strains causing chlorosis and leaf death on maize under greenhouse experiments [22]. Since maize is not one of C. flaccumfaciens’ primary hosts, this shift in the bacterial pathogenicity is quite concerning and has prompted the need for additional research in this area.
The present investigation was conducted with plant samples (showing symptoms of microbial diseases) collected in our previous study in a private vegetable garden, where various vegetables and fruits were grown [41]. Five strains (3t2, 12t1, 3p3, 4p1 and 4p2) not belonging to the common casual agents of bacterial spot and canker diseases were isolated. The observed morphological characteristics and established phenotypic features corresponded with those reported for representatives of the species C. flaccumfaciens and its several pathovars [20,22,50]. Except the yellow- and orange-pigmented colonies, the species was reported to also produce red or pink colonies, and also variants of yellow colonies producing a diffusible water-soluble purple pigment [24,50,51].
The phenotypic characterization of our five isolates revealed that they possessed some of the typical metabolite features reported for the coryneform plant pathogens. Usually, the biochemical features of the strains are not solid bases for their distinguishing, either at the pathovar level or the species level. However, some characteristics (casein hydrolyses) have been used for additional differentiation inside the species C. flaccumfaciens. It has been reported that two pathovars of the species are positive for this feature: the yellow-pigmented strains of pv. flaccumfaciens and pv. oortii [14]. Interestingly, the newly described species C. aurantiacum (formerly C. flaccumfaciens pv. flaccumfaciens), forming pink-, red- and orange-pigmented colonies, has been reported to be negative for this characteristic, as well as C. poinsettiae (formerly C. flaccumfaciens pv. poinsettiae) [14,52]. However, in other studies, red-pigmented variants of the species C. flaccumfaciens (now C. aurantiacum) have been reported to be positive for this phenotypic feature [22]. Among our strains, there is also one orange colony variant, strain Cf 3p3, which is positive for casein hydrolysis. Thus, according to the new taxonomy inside the species C. flaccumfaciens, this strain could be considered as close to either the species C. aurantiacum or C. poinsettiae based on this phenotypic feature [14].
The species identification of our strains was performed by a combination of three approaches. According the results obtained from the MALDI-ToF MS, all strains were identified as C. flaccumfaciens. Over the years, the MALDI–ToF MS has been used as a reliable approach for the identification of C. flaccumfaciens and Cff in particular [17,28,29]. These results were confirmed by sequencing analyses of the 16S rDNA of our strains, revealing an above 99% similarity with the C. flaccumfaciens pv. flaccumfaciens strain 1037 and C. flaccumfaciens LMG 3645, respectively [7,46]. The same percent identity was detected with one more species, C. allii, in the EzBioCloud database. This is not surprising, as the latter species was recently reclassified as a pathovar of the species C. flaccumfaciens [14]. The use of 16S rDNA as an approach in the identification of Curtobacterium strains has been also reported before [25,27,28,29,30]. Our phylogenetic analyses showed that our strains clustered closer to C. flaccumfaciens than to any other representatives of the genus Curtobacterium.
The issue for the presence and the role of plasmids in C. flaccumfaciens pathogenicity has been discussed before [53]. For example, the pathogenicity of C. flaccumfaciens pv. flaccumfaciens strain 1037 on P. vulgaris has been demonstrated, and the role of a linear plasmid pCFF113, carrying genes related to the pathogenicity, has been proposed [46]. We investigated the presence of plasmids in the genome of our strains and established their presence in all strains as well as in the type culture of Cfo. Earlier studies, have reported the absence of plasmids in the genomes of a large number of strains of C. flaccumfacien pv. flaccumfaciens when studied via classical agarose gel electrophoreses [15]. Recent studies based on the sequencing of the genome of one of these strains (P990) have revealed that it contains three plasmids, pCff1, pCff2 and pCff3 [53]. Furthermore, it has been proposed that one of these plasmids (pCff1) harbors genes related to the pathogenicity of the strain, including serine protease, pectate lyase and others [53].
The third method used for the identification of our strains was PCR with the primers CffFor2/CffRev4, targeting a conserved region of the genome of the Cff strains [31]. Our results showed that the expected amplification product (approximately 306 bp) was visualized in the agarose gel electrophoresis only when the plasmid DNA was used as a template in the PCR reactions, and not when cDNA was used. The only exception was strain 12t1, where no amplification products were observed in both the plasmid and cDNA samples. Based on our results, we could suggest that these primers are designed on plasmid DNA.
Our preliminary bioinformatic research in the NCBI database showed that the primers mentioned above and used in this study hybridize specifically to a particular region in the plasmids, which were detected in the genomes of five Cff strains (the accession numbers of the plasmids are as follows: CP041260.1 (plasmid pCff113), CP045288.2 (plasmid pCff1), CP080396.1 (unnamed plasmid), CP074440.1 (plasmid pCff119) and CP071884.1 (plasmid Cff119)). Thus, it could be proposed that positive amplification is expected only if the strain contains plasmids harboring this particular region. These findings are in accordance with our results, suggesting that our strains carry the plasmid of interest. Moreover, no specific data concerning the role of the targeted sequence of these primers have been published. Only one suggestion for the similarity of the putative protein encoded by this sequence with serine proteases found in other species has been assumed [22]. Our bioinformatic research in the NCBI database revealed that the translated amino acid sequence provided a similarity to the trypsin-like serine protease or S1 family peptidase found in other Curtobacterium species.
Based on the results obtained from the three independent approaches, we can conclude that our strains belong to the species C. flaccumfaciens, with great possibility to be attributed to C. flaccumfaciens pv. flaccumfaciens (except strain 12t1). However, further studies on the pathogenicity of our strains on susceptible hosts should be carried out in order to establish their exact pathovar belonging.
To our knowledge, our study is the first report on the isolation of C. flaccumfaciens in Bulgaria at all and the first report of C. flaccumfaciens (strain 12t1) isolated from tomato seeds in particular. Furthermore, the newly isolated strains were obtained in tomato and pepper plants, which are not among the known susceptible hosts of this bacterium. We found no reported data on the isolation of Cf from tomato seeds. The majority of the papers reported the epiphytic or endophytic persistence of Cf in non-host plants and especially on solanaceous vegetables [22,54]. Previous studies aimed at establishing the accompanying microflora (pathogenic, epiphytic and endophytic) of tomato flowers with symptoms of bacterioses have also been conducted before in Bulgaria, but no data on the isolation of C. flaccumfaciens have been reported [55]. In our research, we found that Cf strains coexisted with various species in plant tissues. In the tomato stem sample (T3), the strain 3t2 was found to coexist with Pseudomonas and X. euvesicatoria (data not published). In the seed sample (T12), the strain 12t1 was detected along with P. agglomerans and Enterobacter cloacae [41]. In the pepper leaf sample (P3), the isolate 3p3 coexisted with P. agglomerans, R. larrymoorei and X. euvesicatoria [41]. The chili pepper leaf sample (T4) was found to be inhabited only by Cf strains 4p1 and 4p2, as reported in this study.
An important feature of actinobacteria is the production of various antimicrobial substances [56]. The representatives of genus Curtobacterium as actinobacterial species have been also reported to produce antimicrobial substances [22,57]. The antibacterial action of two Curtobacterium strains against representatives of the so-called “ESKAPE” group (Enterococcus faecium, Staphylococcus aureus, Klebsiella pneumoniae, Acinetobacter baumannii, Pseudomonas aeruginosa and Enterobacter species) have been demonstrated [56]. The deep investigation of such substances derived from ten Cff strains revealed that they belong to a group of temperature-resistant compounds, bacteriocins, and have been named flaccumfacin. Additionally, it has been proposed that the bacteriocins produced from the bacterial wilt pathogen may contribute to its pathogenicity [57]. According to more recent research, the Cff strains’ aggressiveness on common beans positively correlated with their possibility to produce bacteriocins [52]. Thus, the ability of our isolate to produce AMSs, as established in this study, could be considered a key characteristic defining their putative pathogenicity on susceptible and alternate hosts.
In order to enable the implementation of more effective management strategies, in-depth studies on the role of alternative and alternate host plants as natural reservoirs in the lifecycle of phytopathogenic bacteria should be carried out. In this regard, the artificial infection of tomato and pepper plants in this study aimed to establish the ability of our Cf isolates to live and multiply in the vascular systems of plants, which were so far not reported as susceptible host of this bacterium. We also aimed to clarify whether they have accidentally come upon these plants or can inhabit them and therefore use them as natural reservoirs. By inoculating our Cf strains into the xylem of the plants, we aimed to determine whether any morphological changes would develop in the aerial parts of the plants and whether the strains would be viable and successfully recovered after the examined period. A similar study investigating the role of various weeds as natural reservoirs of Cff was conducted by Nascimento et al. [58]. The authors reported that the Cff strain Feji 2628A can survive in the phyllosphere and rhizosphere of several weed species for up to 70 days [58]. Another similar study reported that solanaceous vegetables could also serve as sources for the isolation of Cf strains, i.e., the bacteria persist on them without affecting the plants [22]. In that study, the pathogenic capacity of Cff strains was investigated on several crop species, including tomato, bell pepper, eggplant, maize, common bean, mung bean, cowpeas, soybean, zucchini, faba bean, honeydew melon, rapeseed, sugar beet, sunflower, etc. [22]. However, there was no evidence of the successful re-isolation of Cff strains from artificially infected tomatoes, peppers and eggplants. Expectedly, in that study, Cff strains were successfully re-isolated from the primary host plants as well as from symptomless plants [22].
Unlike in our study, during the investigated period (28 days), we observed the appearance of morphological changes only in tomato plants infected with strains 3t2 and 12t1, but not in the pepper plants. Our assumption was that the persistence of Cf in the vascular system of tomato plants may have an additional impact on the plant’s physiological condition. Furthermore, we successfully re-isolated viable Cf strains from the stem parts of the test plants 28 days after their artificial infection. Our results showed that the 73 re-isolates shared phenotypic features and molecular characteristics, including RAPD-PCR patterns with the original Cf strains that were used for the artificial infection the test plants. RAPD–PCR is a molecular tool that is considered to be highly accurate in identifying a strain’s genome uniqueness, which is useful when a certain strain’s behavior needs be tracked in a variety of contexts. The unique molecular structure of a strain’s genome, identified by RAPD amplification, provides an accurate, fast and straightforward method for monitoring its presence in plants after artificial infection, all without the risk of mistaking the strain with one that might exist in the plant naturally.
5. Conclusions
Numerous questions arise regarding the pathways of plant pathogens and the capacity to adapt their pathogenicity mechanisms to inhabit new ecological niches and expand their host range. The effective management of plant diseases requires in-depth knowledge of the natural reservoirs of plant pathogens. Thus, studies investigating the ability of phytopathogenic bacteria to exploit alternate host plants as reservoirs for survival and spread to susceptible host plants is very important.
To our knowledge, our study is the first report on the isolation and characterization of C. flaccumfaciens in Bulgaria, as well as the first report of its isolation from tomato seeds. The characterization of our isolates showed that they possessed the biological features which refer them to the group of phytopathogenic coryneform bacteria. We demonstrated that tomato and pepper plants can act as reservoirs of this pathogen, finding that it successfully survives in these plants. The morphological changes we observed in the artificially infected tomato plants were close to the symptoms of bacteriosis and raises the question of the pathogenicity of these strains to this plant. More in-depth studies are needed in order to clarify the molecular response of tomato plants to infection with C. flaccumfaciens. We believe that the results obtained from the present study could be a good basis for further in-depth research in this area.
Author Contributions
Conceptualization, Y.K.; methodology, Y.K., P.H. and P.M.; software, Y.K. and P.H.; validation, Y.K., P.H. and P.M.; investigation, Y.K., M.G., M.P., M.D., Y.G., D.D. and D.P.; resources, Y.K. and P.H.; writing—original draft preparation, Y.K.; writing—review and editing, Y.K., P.H., D.D. and P.M.; visualization, Y.K., D.D., D.P. and M.G.; supervision, Y.K.; project administration, Y.K. All authors have read and agreed to the published version of the manuscript.
Funding
This study was supported by National Science Fund of Ministry of Education and Science of Bulgaria, project number KP-06-COST/9/22.05.2024. MALDI-ToF strain identification was performed at the National Reference Laboratory for Control and Monitoring of Antimicrobial Resistance, NCIPD (26 Yanko Sakazov blvd., 1504 Sofia), purchased with support from the European Regional Development Fund through the Operational Program Science and Education for Smart Growth 2014–2020; Grant BG05M2OP001-1.002-0001-C04, “Fundamental Translational and Clinical Research in Infection and Immunity”.
Institutional Review Board Statement
Not applicable.
Informed Consent Statement
Not applicable.
Data Availability Statement
The data presented in this research are available in the manuscript.
Conflicts of Interest
The authors declare no conflicts of interest.
References
- Tarlachkov, S.V.; Starodumova, I.P.; Dorofeeva, L.V.; Prisyazhnaya, N.V.; Roubtsova, T.V.; Chizhov, V.N.; Nadler, S.A.; Subbotin, S.A.; Evtushenko, L.I. Draft Genome Sequences of 28 Actinobacteria of the Family Microbacteriaceae Associated with Nematode-Infected Plants. Microbiol. Resour. Announc. 2021, 10, e01400-20. [Google Scholar] [CrossRef]
- Evtushenko, L.I.; Takeuchi, M. The family Microbacteriaceae. In The prokaryotes: A Handbook on the Biology of Bacteria. Archaea, Bacteria, Firmicutes, Actinomycetes, 3rd ed.; Dworkin, M., Falkow, S., Rosenberg, E., Schleifer, K.-H., Stackebrandt, E., Eds.; Springer: New York, NY, USA, 2006; Volume 3, pp. 1020–1098. [Google Scholar]
- Parte, A.C.; Sardà Carbasse, J.; Meier-Kolthoff, J.P.; Reimer, L.C.; Göker, M. List of Prokaryotic names with Standing in Nomenclature (LPSN) moves to the DSMZ. Int. J. Syst. Evol. Microbiol. 2020, 70, 5607–5612. [Google Scholar] [CrossRef]
- Yamada, K.; Komagata, K. Taxonomic Studies on Coryneform Bacteria. J. Gen. Appl. Microbiol. 1972, 18, 417–431. [Google Scholar] [CrossRef]
- Komagata, K.; Iizuka, K. New Species of Brevibacterium Isolated from Rice. (Studies on the Microorganisms of Cereal grains, Part VII). J. Agric. Chem. Soc. 1964, 38, 496–502. [Google Scholar]
- Aizawa, T.; Ve, N.B.; Kimoto, K.I.; Iwabuchi, N.; Sumida, H.; Hasegawa, I.; Sasaki, S.; Tamura, T.; Kudo, T.; Suzuki, K.I.; et al. Curtobacterium ammoniigenes sp. nov., an ammonia-producing bacterium isolated from plants inhabiting acidic swamps in actual acid aulfate soil areas of Vietnam. Int. J. Syst. Evol. Microbiol. 2007, 57, 1447–1452. [Google Scholar] [CrossRef]
- Behrendt, U.; Ulrich, A.; Schumann, P.; Naumann, D.; Suzuki, K. Diversity of Grass-Associated Microbacteriaceae Isolated from the Phyllosphere and Litter Layer after Mulching the Sward; Polyphasic Characterization of Subtercola pratensis sp. nov., Curtobacterium herbarum sp. nov. and Plantibacter flavus Gen. nov., sp. nov. Int. J. Syst. Evol. Microbiol. 2002, 52, 1441–1454. [Google Scholar]
- Carty, C.E.; Litchfield, C.D. Characterization of a New Marine Sedimentary Bacterium as Flavobacterium oceanosedimentum sp. nov. Int. J. Syst. Bacteriol. 1978, 28, 561–566. [Google Scholar] [CrossRef]
- Hedges, F.A. Bacterial Wilt of the Bean Caused by Bacterium flaccumfaciens Nov. sp. Science 1922, 55, 433–434. [Google Scholar] [CrossRef]
- Collins, M.D.; Jones, D.Y. Reclassification of Corynebacterium flaccumfaciens, Corynebacterium betae, Corynebacterium oortii and Corynebacterium poinsettiae in the Genus Curtobacterium, as Curtobacterium flaccumfaciens Comb. Nov. Microbiology 1983, 129, 3545–3548. [Google Scholar] [CrossRef]
- Feng, G.D.; Li, J.; Yang, S.; Zhang, J.; Zhu, H. Curtobacterium caseinilyticum sp. nov., Curtobacterium subtropicum sp. nov. and Curtobacterium citri sp. nov., isolated from citrus phyllosphere. Int. J. Syst. Evol. Microbiol. 2023, 73, 006152. [Google Scholar] [CrossRef]
- Seaton, S.; Lemaire, J.; Inderbitzin, P.; Knight-Connoni, V.; White, J.F.; Trujillo, M.E. Curtobacterium glycinis sp. nov. from Glycine max, Curtobacterium gossypii sp. nov. from Gossypium hirsutum and Curtobacterium oryzae sp. nov. from Oryza sativa, three new Curtobacterium species and endophytes from agricultural crops. bioRxiv, 2021. [Google Scholar] [CrossRef]
- Khanal, M.; Bhatta, B.P.; Timilsina, S.; Ghimire, S.; Cochran, K.; Malla, S. Curtobacterium allii sp. nov., the actinobacterial pathogen causing onion bulb rot. Antonie Van Leeuwenhoek 2023, 116, 83–96. [Google Scholar] [CrossRef]
- Osdaghi, E.; Taghavi, S.M.; Hamidizade, M.; Kariminejhad, M.; Fazliarab, A.; Hajian Maleki, H.; Baeyen, S.; Taghouti, G.; Jacques, M.A.; Van Vaerenbergh, J.; et al. Multiphasic investigations imply transfer of orange-/red-pigmented strains of the bean pathogen Curtobacterium flaccumfaciens pv. flaccumfaciens to a new species as C. aurantiacum sp. nov., elevation of the poinsettia pathogen C. flaccumfaciens pv. poinsettiae to the species level as C. poinsettiae sp. nov., and synonymy of C. albidum with C. citreum. Syst. Appl. Microbiol. 2024, 47, 126489. [Google Scholar]
- Osdaghi, E.; Taghavi, S.M.; Calamai, S.; Biancalani, C.; Cerboneschi, M.; Tegli, S.; Harveson, R.M. Phenotypic and Molecular-Phylogenetic Analysis Provide Novel Insights into the Diversity of Curtobacterium flaccumfaciens. Phytopathology 2018, 108, 1154–1164. [Google Scholar] [CrossRef]
- Funke, G.; Aravena-Roman, M.; Frodl, R. First description of Curtobacterium spp. isolated from human clinical specimens. J. Clin. Microbiol. 2005, 43, 1032–1036. [Google Scholar] [CrossRef]
- Mallick, P. A rare case of Curtobacterium flaccumfaciens infection in the eye: A case report. Trop. Med. Health 2022, 50, 64. [Google Scholar] [CrossRef]
- Bulgari, D.; Casati, P.; Crepaldi, P.; Daffonchio, D.; Quaglino, F.; Brusetti, L.; Bianco, P.A. Restructuring of endophytic bacterial communities in grapevine yellows-diseased and recovered Vitis vinifera L. plants. Appl. Environ.Microbiol. 2011, 77, 5018–5022. [Google Scholar] [CrossRef]
- Lacava, P.T.; Li, W.; Arauújo, W.L.; Azevedo, J.L.; Hartung, J.S. The endophyte Curtobacterium flaccumfaciens reduces symptoms caused by Xylella fastidiosa in Catharanthus roseus. J. Microbiol. 2007, 45, 388–393. [Google Scholar]
- EPPO (European and Mediterranean Plant Protection Organization). Curtobacterium flaccumfaciens pv. flaccumfaciens. EPPO Bull. 2011, 41, 320–328.
- EFSA Panel on Plant Health (EFSA PLH Panel); Jeger, M.; Bragard, C.; Caffier, D.; Candresse, T.; Chatzivassiliou, E.; Dehnen-Schmutz, K.; Gilioli, G.; Grégoire, J.C.; Jaques Miret, J.A. Pest categorisation of Curtobacterium flaccumfaciens pv. flaccumfaciens. EFSA J. 2018, 16, e5299. [Google Scholar]
- Osdaghi, E.; Taghavi, S.M.; Hamzehzarghan, H.; Fazliarab, A.; Harveson, R.M.; Tegli, S.; Lamichhane, J.R. Epiphytic Curtobacterium flaccumfaciens strains isolated from symptomless solanaceous vegetables are pathogenic on leguminous but not on solanaceous plants. Plant Pathol. 2018, 67, 388–398. [Google Scholar] [CrossRef]
- Tokmakova, A.D.; Tarakanov, R.I.; Lukianova, A.A.; Evseev, P.V.; Dorofeeva, L.V.; Ignatov, A.N.; Dzhalilov, F.S.-U.; Subbotin, S.A.; Miroshnikov, K.A. Phytopathogenic Curtobacterium flaccumfaciens Strains Circulating on Leguminous Plants, Alternative Hosts and Weeds in Russia. Plants 2024, 13, 667. [Google Scholar] [CrossRef]
- Harveson, R.M.; Schwartz, H.F.; Urrea, C.A.; Yonts, C.D. Bacterial Wilt of Dry-Edible Beans in the Central High Plains of the U.S.: Past, Present, and Future. Plant Dis. 2015, 99, 1665–1677. [Google Scholar] [CrossRef]
- Enya, J.; Shinohara, H.; Yoshida, S.; Tsukiboshi, T.; Negishi, H.; Suyama, K.; Tsushima, S. Culturable Leaf-Associated Bacteria on Tomato Plants and Their Potential as Biological Control Agents. Microb. Ecol. 2007, 53, 524–536. [Google Scholar] [CrossRef]
- Chen, Y.F.; Yin, Y.N.; Zhang, X.M.; Guo, J.H. Curtobacterium flaccumfaciens pv. beticola, A New Pathovar of Pathogens in Sugar Beet. Plant Dis. 2007, 91, 677–684. [Google Scholar]
- Krimi, Z.; Alim, D.; Djellout, H.; Tafifet, L.; Mohamed-Mahmoud, F.; Raio, A. Bacterial endophytes of weeds are effective biocontrol agents of Agrobacterium spp., Pectobacterium spp., and promote growth of tomato plants. Phytopathol. Mediterr. 2016, 55, 184–196. [Google Scholar]
- Pilik, R.I.; Tesic, S.; Ignatov, A.N.; Tarakanov, R.I.; Dorofeeva, L.V.; Lukianova, A.A.; Evseev, P.V.; Dzhalilov, F.S.; Miroshnikov, K.A. First Report of Curtobacterium flaccumfaciens pv. flaccumfaciens Causing Bacterial Wilt and Blight on Sunflower in Russia. Plant Dis. 2023, 107, 1621. [Google Scholar]
- Tarakanov, R.I.; Lukianova, A.A.; Pilik, R.I.; Evseev, P.V.; Miroshnikov, K.A.; Dzhalilov, F.S.; Tesic, S.; Ignatov, A.N. First report of Curtobacterium flaccumfaciens pv. flaccumfaciens Causing Bacterial Tan Spot of Soybean in Russia. Plant Dis. 2023, 107, 2211. [Google Scholar]
- Osdaghi, E.; Taghavi, S.M.; Fazliarab, A.; Elahifard, E.; Jay Ram Lamichhane, J.R. Characterization, geographic distribution and host range of Curtobacterium flaccumfaciens: An emerging bacterial pathogen in Iran. Crop Prot. 2015, 78, 185–192. [Google Scholar] [CrossRef]
- Tegli, S.; Sereni, A.; Surico, G. PCR-based assay for the detection of Curtobacterium flaccumfaciens pv. flaccumfaciens in bean seeds. Lett. Appl. Microbiol. 2002, 35, 331–337. [Google Scholar] [CrossRef]
- Guimaraĕs, P.M.; Palmano, S.; Smith, J.J.; Grossi de Sa, M.F.; Saddler, G.S. Development of a PCR test for the detection of Curtobacterium flaccumfaciens pv. flaccumfaciens. Antonie Van Leeuwenhoek 2001, 80, 1–10. [Google Scholar] [CrossRef]
- Agarkova, I.V.; Lambrecht, P.A.; Vidaver, A.K.; Harveson, R.M. Genetic diversity among Curtobacterium flaccumfaciens pv. flaccumfaciens populations in the American high plains. Can. J. Microbiol. 2012, 58, 788–801. [Google Scholar]
- Guimaraĕs, P.M.; Smith, J.J.; Palmano, S.; Saddler, G.S. Characterisation of Curtobacterium flaccumfaciens Pathovars by AFLP, rep-PCR and Pulsed-Field Gel Electrophoresis. Eur. J. Plant Pathol. 2003, 109, 817–825. [Google Scholar] [CrossRef]
- Gonçalves, R.M.; Balbi-Peña, M.I.; Soman, J.M.; Maringoni, A.C.; Taghouti, G.; Fischer-Le Saux, M.; Portier, P. Genetic Diversity of Curtobacterium flaccumfaciens revealed by multilocus sequence analysis. Eur. J. Plant Pathol. 2019, 154, 189–202. [Google Scholar] [CrossRef]
- Chen, Y.; Guo, J.; Fang, Z. A new pathovar of Curtobacterium flaccumfaciens on malabar spinach. Acta Phytopathol. Sin. 2000, 30, 171–175. [Google Scholar]
- EPPO Global Database. Available online: https://gd.eppo.int/taxon/CORBFL/distribution/BG (accessed on 20 January 2024).
- Kizheva, Y.; Vancheva, T.; Hristova, P.; Stoyanova, M.; Stojanovska, M.; Moncheva, P.; Bogatzevska, N. Identification of Xanthomonas strains from tomato and pepper and their sensitivity to antibiotics and copper. Bulg. J. Agric. Sci. 2013, 19, 80–82. [Google Scholar]
- Kizheva, Y.; Vancheva, T.T.; Stoyanova, M.; Bogatzevska, N.; Moncheva, P.; Hristova, P. 16S-23S ITS rDNA PCR-RFLP Approach as a tool for identification and differentiation of bacterial spot-causing Xanthomonas. J. Plant Pathol. 2016, 98, 645–649. [Google Scholar]
- Bogatzevska, N.; Vancheva-Ebben, T.; Vasileva, K.; Kizheva, Y.; Moncheva, P. An overview of the diversity of pathogens causing bacterial spot on tomato and pepper in Bulgaria. Bulg. J. Agric. Sci. 2021, 27, 137–146. [Google Scholar]
- Kizheva, Y.; Georgiev, G.; Donchev, D.; Dimitrova, M.; Pandova, M.; Rasheva, I.; Hristova, P. Cross-Over Pathogenic Bacteria Detected in Infected Tomatoes (Solanum lycopersicum L.) and Peppers (Capsicum annuum L.) in Bulgaria. Pathogens 2022, 11, 1507. [Google Scholar] [CrossRef]
- Lane, D.J. 16S/23S rRNA Sequencing. In Nucleic Acid Techniques in Bacterial Systematics; Stackebrandt, E., Goodfellow, M., Eds.; John Wiley and Sons: New York, NY, USA, 1991; pp. 115–175. [Google Scholar]
- Yoon, S.H.; Ha, S.M.; Kwon, S.; Lim, J.; Kim, Y.; Seo, H.; Chun, J. Introducing EzBioCloud: A taxonomically united database of 16S rRNA and whole genome assemblies. Int. J. Syst. Evol. Microbiol. 2017, 67, 1613–1617. [Google Scholar] [CrossRef]
- Letunic, I.; Bork, P. Interactive Tree Of Life (iTOL) v5: An online tool for phylogenetic tree display and annotation. Nucleic Acids Res. 2021, 49, W293–W296. [Google Scholar] [CrossRef]
- Momol, M.T.; Momol, E.A.; Lamboy, W.F.; Norelli, J.L.; Beer, S.V.; Aldwinckle, H.S. Characterization of Erwinia amylovora strains using random amplified polymorphic DNA fragment (RAPDs). J. Appl. Microbiol. 1997, 82, 389–398. [Google Scholar] [CrossRef]
- O’Leary, M.; Gilbertson, R. Complete Genome Sequence Resource of a Strain of Curtobacterium flaccumfaciens pv. flaccumfaciens, the Causal Agent of Bacterial Wilt of Common Bean, from Turkey. Phytopathology 2020, 110, 2010–2013. [Google Scholar] [CrossRef]
- Kumar, S.; Bhowmick, M.K.; Ray, P. Weeds as alternate and alternative hosts of crop pests. Indian J. Weed Sci. 2021, 53, 14–29. [Google Scholar] [CrossRef]
- Araújo, E.R.; Costa, J.R.; Pontes, N.C.; Quezado-Duval, A.M. Xanthomonas perforans and X. gardneri associated with bacterial leaf spot on weeds in Brazilian tomato fields. Eur. J. Plant Pathol. 2015, 143, 543–548. [Google Scholar] [CrossRef]
- Kizheva, Y.; Urshev, Z.; Rasheva, I.; Vancheva, T.; Hristova, P.; Bogatzevska, N.; Moncheva, P. PFGE: A tool for examination of heterogeneity between the bacterial spot-causing xanthomonads of tomato plants in Bulgaria. Z. Naturforsch. C J. Biosci. 2018, 73, 257–264. [Google Scholar] [CrossRef]
- Osdaghi, E.; Taghavi, S.M.; Hamzehzarghani, H.; Fazliarab, A.; Harveson, R.M.; Lamichhane, J.R. Occurrence and characterization of a new red-pigmented variant of Curtobacterium flaccumfaciens, the causal agent of bacterial wilt of edible dry beans in Iran. Eur. J. Plant Pathol. 2016, 146, 129–145. [Google Scholar] [CrossRef]
- Osdaghi, E.; Lak, M.R. Occurrence of a new orange variant of Curtobacterium flaccumfaciens pv. flaccumfaciens, causing common bean wilt in Iran. J. Phytopathol. 2015, 163, 867–871. [Google Scholar]
- Osdaghi, E.; Young, A.J.; Harveson, R.M. Bacterial wilt of dry beans caused by Curtobacterium flaccumfaciens pv. flaccumfaciens. A new threat from an old enemy. Mol. Plant Pathol. 2020, 21, 605–621. [Google Scholar]
- Chen, G.; Khojasteh, M.; Taheri-Dehkordi, A.; Taghavi, S.M.; Rahimi, T.; Osdaghi, E. Complete Genome Sequencing Provides Novel Insight into the Virulence Repertories and Phylogenetic Position of Dry Beans Pathogen Curtobacterium flaccumfaciens pv. flaccumfaciens. Phytopathology 2021, 111, 268–280. [Google Scholar] [CrossRef]
- Krimi, Z.; Ziouche, C.; Tafifet, L.; Djellout, H.; Mohamed-Mahmoud, F.; Raio, A. Euphorbia helioscopia a Putative Plant Reservoir of Pathogenic Curtobacterium flaccumfaciens. Curr. Microbiol. 2023, 80, 154. [Google Scholar] [CrossRef]
- Vasileva, K.; Ganeva, D.; Bogatzevska, N. Species composition of the bacterial Population colonizing tomato flowers. Bulg. J. Agric. Sci. 2022, 28, 677–690. [Google Scholar]
- Wang, T.; Li, F.; Lu, Q.; Wu, G.; Jiang, Z.; Liu, S.; Habden, X.; Razumova, E.A.; Osterman, I.A.; Sergiev, P.V.; et al. Diversity, novelty, antimicrobial activity, and new antibiotics of cultivable endophytic actinobacteria isolated from psammophytes collected from Taklamakan Desert. J. Pharm. Anal. 2021, 11, 241–250. [Google Scholar] [CrossRef]
- Gross, D.C.; Vidaver, A.K. Bacteriocins of phytopathogenic Corynebacterium species. Can. J. Microbiol. 1979, 25, 367–374. [Google Scholar] [CrossRef]
- Nascimento, D.M.; Oliveira, L.R.; Melo, L.L.; Silva, J.C.; Soman, J.M.; Girotto, K.T.; Eburneo, R.P.; Ribeiro-Junior, M.R.; Sartori, M.M.P.; Silva-Junior, T.A.F.; et al. Survival of Curtobacterium flaccumfaciens pv. flaccumfaciens in weeds. Plant Pathol. 2020, 69, 1357–1367. [Google Scholar] [CrossRef]
Disclaimer/Publisher’s Note: The statements, opinions and data contained in all publications are solely those of the individual author(s) and contributor(s) and not of MDPI and/or the editor(s). MDPI and/or the editor(s) disclaim responsibility for any injury to people or property resulting from any ideas, methods, instructions or products referred to in the content. |
© 2024 by the authors. Licensee MDPI, Basel, Switzerland. This article is an open access article distributed under the terms and conditions of the Creative Commons Attribution (CC BY) license (https://creativecommons.org/licenses/by/4.0/).